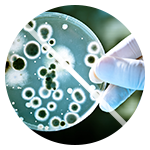
Дезінфекція

Ми знищимо будь-яких шкідників
Традиційні засоби боротьби з комахами в житлових приміщеннях приносять бажаний ефект тільки в окремих випадках. Дезінсекція тарганів, клопів, кліщів та інших шкідників за допомогою саморобних отрут і вузькоспеціалізованих хімічних складів дозволяє тимчасово вирішити проблему з напливом паразитів. Однак через нетривалий проміжок часу ця складність може з'явитися знову.
Тотальна дезінсекція
Для повного очищення приміщень від клопів і тарганів необхідно застосовувати комплексний підхід. Служба дезінсекції завжди оперативно реагує на запити клієнтів і в найкоротші терміни позбавляє від напливу шкідників.
Нам довіряють